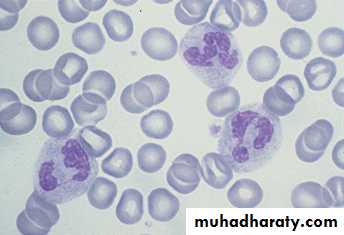

• Introduction To Immunology
• Dr.Firas Al-Tae• MBChB, University of Mosul, Iraq
• PhD Immunology, University of Liverpool, UK
Immunology: Science deals with :
Body protective and defense mechanisms against diseases (infections and tumours)Clearance of dead cells and tissue repair
Vaccination
Allergy and hypersensitivity
Tissue transplantation and transplant rejection
Autoimmunity ...etc..
Immunity:
• Original meaning• "Exemption from government taxes"
• In the context of immunology
• "Collective defense mechanisms against diseases"
The body system (cells, organs and molecules) responsible for the immunity is called the immune system
• Immune response
The effort of the immune system in regards to any etiological agent
Usually against foreign immunogens, useful
Sometimes harmful !!!!!!!!
• Graft rejection
• Autoimmunity: against self immunogens
Self vs nonself immunogens
Antigens (Ags)
Foreign substance ---- AntigenIf able to produce immune response ------- immunogen or complete antigen
If unable to initiate immune response alone called partial antigen
All immunogens are antigenic but not all antigens are immunogenic
Immune system does not react against the whole pathogen but parts of it (Ags) and not against the whole Ag but parts of it (chemical groups) called epitopes
Each Ag has variable number of epitopes
Properties of Antigens
• 1. ForeignnessA) Autologous antigens : Self antigens and there will be no immune response.
B) Allogenic antigens : from the same species and there may be reaction, eg. Blood transfusion, kidney transplant
C) Heterologous antigens: from different species.These antigens will be rejected and there will be severe immune response
Properties of Antigens
• 2. Chemical complexity
• Most antigens contain at least one amino acid in their structures. More amino acid more antigenicity
• 3. Molecular weight
• More than 100,000 Dalton more immunogenic
- Not present at birth but acquired during life as immune system develops
- Late , starts days after first infection- Specific, reacts specifically with specific immunological molecules
(antigens)Adaptive (specific) immunity
- Present from birth
- Our First Line Of Defense
- Rapid starts within min-hours after encountering pathogens- Non specific prevents almost ALL pathogens from causing diseases;
Types of Immunity
Innate (non-specific) immunity
- Memory cells
Aquired (specific) immunity
- No memory cells
Types of Immunity- continue
Innate (non-specific) immunity•
“Memory” in adaptive immunity
• 1st infection memory 2nd infection• Slow response Fast response
• Pathogen proliferates Pathogen being killed
• Disease No disease Symptoms No symptoms
Elements of Innate and Adaptive Immunity
Elements of Innate Imuunity1. Epithelial Barriers (Skin , Mucosal Tissues ,
GIT flora , Lysozymes and extracellular fluids)
- Act as physical or chemical barriers
- Structural integrity of skin and muous membranes prevent -
COLONIZATION
- Damaged surfaces—abraded skin are often readily colonized promoting invasion of skin and other tissues
Chemical and Physical Barriers-The Skin
Microorganisms normally associated with skin prevent potential pathogens from
"Colonizing".Sebaceous glands secrete
fatty acids and lactic acidwhich lower the skin pH
(pH 4-6)
Skin integrity itself acts as barrier that prevents colonization
The skin has a low moisture content
Chemical and PhysicalBarriers-Mucosal membranes
Ciliated epithelial cells lining the trachea remove microbes inhaled
through the nose and mouth.Mucus secreted by these cells prevent the microbes from associating
"Too closely" with the cellsCilia push microbes upwards until they are caught in oral secretions
and expectorated or swallowed.Chemical and Physical Barriers-Normal Flora of the Gastrointestinal Tract
Chemical and Physical Barriers-Lysozyme of the eye and kidney
Lysozymes constantly bath the kidney and the surface of the eye (tears).
(also in the female urogenital tract, and saliva)
Lysozyme breaks the glycosidic bonds between the NAG and NAMthat make up the backbone of peptidoglycan—causing bacteria to lyse.
Chemical and Physical Barriers-Extracellular fluids
Blood plasma contains bacteriocidal substancesBlood proteins called beta-lysins bind to and disrupt the bacterial
cytoplasmic membrane—leads to leakage of the cytoplasmic constituentsand bacterial cell death
Elements of Innate Immunity
2. Phagocytes- Cells that engulf, digest and destroy pathogens
- Include :
- Neutrophils
- Monocytes/Macrophages
- Natural Killer (NK) cells
• Neutrophils
Multi-lobular nucleus (PMNLHighly mobile phagocytes
Acute inflammation
Containing bacteria-killing enzymes
Elements of Innate Immunity
- Tissues- 5-10 times larger
- More phagocytic activity
- Named Based on Tissue They Reside
Alveolar (lungs), Kupffer (liver), Microglial (brain), Osteoclasts (bone)
- Blood
- Smaller
Elements of Innate Immunity
Monocytes/Macrophages
• Natural Killer (NK) cells (CD56+)
• - Large round granular lymphocytes• - Always remain in the circulation
• - Act as immunological surveyors (cytotoxic cells) Kill virally infected cells
• Kill tumours
However, NK cells do not require stimulation, nor they do exhibit memory cells. NK cells respond in the absence of MHC proteins.
What does CD refer to???????
Elements of Innate Immunity
CD (Cluster of Differentiation)CD = Cluster of differentiation
Leukocytes surface antigens that are expressed on cells of a particular lineage “differentiation”
Also called CD molecules , CD antigens , CD markers
Used to classify leukocytes into functionally distinct subpopulation, e.g
NK cells are CD56+
T - Lymphocytes CD3+ (pan T cells marker)
B - Lymphocytes CD19+
Monocytes / Macrophages CD14+
The Specific Immune Response
• - Non-specific (innate) immunity IS SOMETIMES NOT ENOUGH!!!
• - Another more poweful type of immunity called specific (adaptive) immunity is required —That ACQUIRED ability to recognize and destroy an individual pathogen and its products- Specific Immunity results from the actions of B- and T- lymphocytes present in the blood and lymph ( key players)
- Lymph is distinguished from blood in that it does NOT contain red blood cells.
All immune cells including B and T lymphocytes are bone marrow-derived distributed through out the bodyStem cells are the precursors to all of these cells
Origin and Development of B - and T - LymphocytesOrigin : Stem cells in the bone marrow
Maturation : Bone marrow (B cell maturation)
• Thymus ( T cell maturation)
• - From 1ry lymphoid organs distributed through
• lymph and blood to 2ry lymphoid organs:
• Lymph nodes
• Tonsils
• Spleen
• Mucosal tissues in lung and gut
1 ry lymphoid organs
Types of specific (adaptive) immunity
Humoral immunityCellular immunity
Overview of the specific (adaptive) immune response
1. Cell Mediated Immunity ( T cell mediated immunty)Key players : T - lymphocytes. Two types:
Cytotoxic T cells (CTL) or (CD8+)T helpers ( TH) cells (CD4+)
- Cytotoxic T cells directly attack and destroy antigen-bearing cells especialy
virally infected cells and tumours
- Helper T cells act indirectly by secreting proteins called cytokines that
activate other cells such as macrophages to destroy the antigen-bearing cellsCAN you name another immunological cell type that also functions as
CYTOTOXIC cells ?????.What are the main differences between them?
Mechanism of cytotoxicity by CTL (CD8) +
T - lymphocytes CAN NOT recognize and respond to free antigens
T lymphocytes
+
Free antigens
=
No action
Mechanism of cytotoxicity by CTL (CD8+)
1st step : virally infected or tumour transformed cells will be engulfed by the phagocytes (macrophages) at the site of infection or transformation (internalization)Next , internalized antigen is processed inside the macrophages where the antigen is degraded and fragment of it binds to MHC class I molecule (Major Histocompatibility Class I molecule)
Major Histocompatibility complex proteins are found on the surface of cells:: T cells cannot recognize foreign antigens unless they are associated with these MHC proteins
Class I MHC proteins are
found on the surface of ALL
nucleated cells
Class II MHC proteins are only
found on the surface of
B lymphocytes, macrophages
and other antigen presenting cells
ALL MHC proteins are imbedded in the cytoplasmic membrane of
cells and project outward from the cell surface
Mechanism of cytotoxicity by CTL (CD8+)
THEN , the processed antigens bind to Class I
• (Ag-MHC class I complex ) are transported to the cell surface
- The phagocytes ( macrophages) now move toward regional lymph nodes under the influence of certain chemical substances (chemotaxis)
Mechanism of cytotoxicity by CTL (CD8+)
In the regional lymph nodes the phagocytes present the antigen in association with MHC class I molecule to lymphocytes.That is why phagocytes ( macrophages) are called antigen presenting cells (APC)
Mechanism of cytotoxicity by CTL (CD8+)CTL interact SPECIFICALLY with the antigen - MHC class I complex through TCR (T Cell Receptor).
Each T cell has thousands of copies of the SAME TCR on its surface
The immune system can generate TCRs that will bind nearly every known peptide antigenThe TCR can only recognize and bind a peptide antigen if the antigen is bound first to MHC proteins
Structure of the T-cell receptor (TCR). The V domains of the alpha chain and beta chain combine to form the peptide antigen-binding site.
Cytoplasmic membrane of
a T cell
The T cell receptor extends
from the surface of a T cell
Class I MHC proteins and cytotoxic T cells (Tc)
Class I pathway is useful in destroyingcells that have been infected by viruses or
have been transformed by tumors
1. Protein antigens manufactured in the cell
by viruses or tumors are degraded in the
cytoplasm and transported to the
endoplasmic reticulum
2. The processed antigens bind to Class I
MHCs and are transported to the cell
surface
3. Together this complex interacts with the
TCR of a Tc cell, the binding of the
complex with the TCR is strengthened
buy a CD8 coreceptor
Class I MHC proteins and cytotoxic T cells (Tc)
The cell-cell interaction between
the infected cell and the Tc
cell is mediated by the
MHC class I - antigen complex and TCR
The Tc cell produces cytotoxic proteins
perforins—produce holes or pores in the
target cell and granzymes enter the
virus infected cell causing apoptosis or
programmed cell death
The cytotoxic proteins only affect those
cells to which the Tc cell has specificallyinteracted
Mechanism of cytotoxicity by CTL (CD8+)
The first contact of the CTL with the antigen is called primary immune response. This will take time to develope (usually several days) and associated with development of memory cells.When the CTL come in contact with same antigen for second time , this is called secondary immune response.Usually faster than 1ry immune reponse and more stronger that leads to eradication of pathogen before symptoms appear.